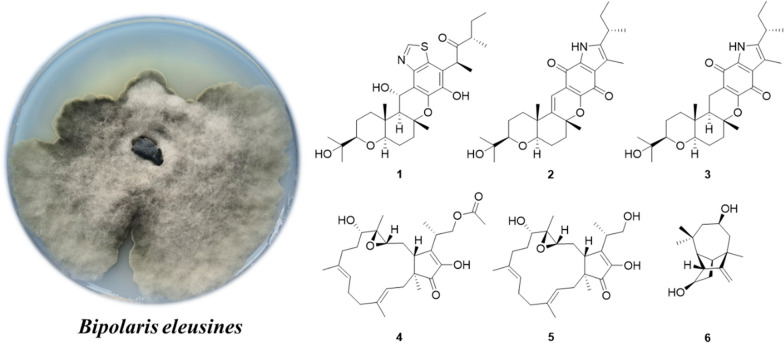
graphic file with name 13659_2023_407_Figa_HTML.jpg

Abstract
A series of terpenoids (1–17), comprising six new compounds designated bipolariterpenes A-F (1–6) and eleven recognized compounds (7–17), were isolated from the wheat culture of the potato endophytic fungus Bipolaris eleusines. Their structures and stereochemistry were clarified by HRESIMS, NMR, DP4 + probability analyses, and computations for electronic circular dichroism (ECD). All compounds are made up of six meroterpenoids, four sesterterpenes and seven sesquiterpenes. Among them, four sesterterpenes (4, 5, 10, 11) were investigated for their antifungal, antibacterial and cytotoxic properties, and six meroterpenoids (1–3, 7–9) were evaluated for their antifungal properties. The compounds 7, 9, and 10 had substantial antifungal activity against Epidermophyton floccosum at a concentration of 100 µM. No antibacterial and cytotoxic activities were observed.
Graphical Abstract
Supplementary Information
The online version contains supplementary material available at 10.1007/s13659-023-00407-x.
Keywords: Endophytic fungus, Bipolariseleusines, Terpenoids, Isolation and structure elucidation, Antifungal activity
Introduction
Terpenoids, possessed several hundred initial terpene scaffolds, are very important secondary metabolites [1]. Terpenoids have a basic unifying trait that all terpenoids are derived from the five carbon precursor molecules dimethylallyl diphosphate and isopentenyl diphosphate [2]. According to their chemical skeletons, terpenoids are further categorized into monoterpenes, sesquiterpenes, diterpenes, sesterterpenes and triterpenes as well as meroterpenoids derived from the hybridization of polyketide and terpenoid [3]. Terpenoids offer a wide spectrum of biological functions, such as the cancer-fighting monoterpene carvacrol [4], the sesquiterpene atractylenolide V with anti-inflammatory effects [5], and the diterpene 7-deoxynimbidiol with antioxidant activity [6]. One of the most important sources of terpenoids is endophytic fungi, which have been widely reported to have specific biosynthetic capabilities [7, 8]. As a result, the metabolites of endophytic fungi deserve to be further investigated.
Bipolaris is a genus of fungi belonging to the family Pleosporaceae [9, 14], and many metabolites have been reported from several species of this genus, such as terpenes, polyketides, quinones, peptides and alkaloids [10, 11, 14]. The majority of them have a wide spectrum of beneficial biological qualities, such as antifungal, antibacterial, and cytotoxic properties [12–14]. In our previous study on B. eleusines, a series of meroterpenoids, sesquiterpenes and chromones have been characterized [14–16]. Among them, bipolarithizole A, a new phenylthiazole-sativene merosesquiterpenoid having a MIC value of 16 μg/mL, inhibited Rhizoctonia solani [14]. To find more potent biological agents, a chemical study on B. eleusines with a large-scale fermentation was carried out. As a result, seventeen terpenoids, including six undescribed compounds, were isolated from cultures of the fungus B. eleusines. The details of its isolation, structural elucidation, and antifungal, antibacterial as well as cytotoxic activities are reported in this paper (Fig. 1).
Fig. 1.
The chemical structures of compounds 1–17
Results and discussion
Compound 1 was purified as a colorless solid. The protonated molecule signal in the HRESIMS was used to calculate its chemical formula, which was C29H41NO6S (10 indices of hydrogen deficiency). The 1H NMR spectrum of 1 (Table 1) revealed indications for seven methyl groups [δH 0.85 (t, J = 7.4 Hz), 1.20 (s), 1.19 (s), 1.11 (s), 1.36 (s), 1.44 (d, J = 7.1 Hz) and 0.76 (d, J = 6.6 Hz)], two oxymethine protons [δH 3.29 (m), and 3.26 (m)], as well as a number of aliphatic methylene multiplets. In connection with the DEPT experiment, the 13C NMR spectrum (Table 1) revealed 29 carbon resonances traceable to seven methyls, five methylenes, seven methines and ten quaternary carbons. The one-dimensional (1D) NMR data of 1 were quite similar to those of known substance 19-dehydroxyl-3-epi-arthripenoid A [17], which is a meroterpenoid with sesquiterpenoid and polyketide components. This was followed by more research into the HMBC and 1H − 1H COSY spectra, which confirmed the planar structure of 1. The sesquiterpenoid unit (C-12–C-26) was calculated from the 1H–1H COSY correlations of H2-19/H2-20/H-21, H2-15/H2-16/H-17 and H2-12/H-13 as well as HMBC cross-peaks from H3-23 to C-21, C-22, and C-24, from H3-26 to C-13, C-14, and C-15, and from H2-12 to C-13 and C-14 (Fig. 2). The polyketide unit (C-1–C-11, C-27 and C-28) was clarified using the 1H–1H COSY correlations of H3-1/H2-2/H-3, as well as HMBC cross-peaks from H3-28 to C-2, C-3, and C-4 and from H-27 to C-4, C-5, and C-6 (Fig. 2). Following that, the two units were linked using the HMBC cross-peaks from H2-12 to C-8, C-9, C-10, C-13, C-14 and C-18. Furthermore, the ROESY correlations of H-21 (δH 3.29)/H-19α (δH 1.49)/H-17 (δH 3.26)/H-13 (δH 2.00) and H-19β (δH 2.68)/H3-25(δH 1.11)/H3-26 (δH 1.36)/H-12 (δH 5.49) proposed that H-21, H-17, and H-13 were α-oriented, whereas H3-26, H3-25 and H-12 were β-oriented in the sesquiterpenoid section (Fig. 3). Based on prior discoveries from single crystal X-ray diffraction and the stereoselectivity of enzymes in biosynthesis, the relative configuration of C-5 is known to be fixed (5S-configuration) [18, 19]. The absolute configuration of C-3 can be determined using the diagnostic chemical shift of C-2. The 13C chemical shift values at the C-2 location are substantially downshifted (δC 26.8 for 3S and δC 23.6 for 3R), as reported for the 3S-conformation [18]. Therefore, the chemical shifts of C-2 at δC 27.3 in 1 revealed that C-3 is S-configured. The proposed structure of 1 was further confirmed by the quantum chemical calculations of the NMR data (qccNMR) of two diastereoisomers (3S-1 and 3R-1). The two epimers were submitted to a thorough conformational screening approach, and the NMR chemical shifts were estimated using the PCM solvent model in methanol at the mPW1PW91/6–31 + G(d,p)//M06-2X/def2-SVP level of theory. As a result, the calculated 13C NMR data for 3S-1 agreed well with its experimental values and DP4 + analysis also identified 3S-1 as the most instructive structure of 1 with 100% DP4 + chance for all data (Fig. 4 and Additional file 1: Fig. S78). Therefore, compound 1 was defined as (3S,5S,12S,13S,14R,17R,18R,21R)-1.
Table 1.
1H (600 MHz) and 13C (150 MHz) NMR data of compounds 1–3
| No. | 1b | 2a | 3b | |||
|---|---|---|---|---|---|---|
| δC, type | δH (J in Hz) | δC, type | δH (J in Hz) | δC, type | δH (J in Hz) | |
| 1 | 11.6, CH3 | 0.85, t (7.4) | 12.2, CH3 | 0.85, t (7.4) | 12.6, CH3 | 0.72, t (7.3) |
| 2 | 27.3, CH2 | 1.64, m | 29.8, CH2 | 1.62, m | 30.2, CH2 | 1.54, m |
| 1.40, m | ||||||
| 3 | 45.3, CH | 2.48, m | 32.3, CH | 2.84, m | 33.7, CH | 2.67, m |
| 4 | 213.4, C | 141.6, C | 140.2, C | |||
| 5 | 45.6, CH | 4.50, q (7.0) | 118.5, C | 120.2, C | ||
| 6 | 117.5, C | 122.5, C | 120.0, C | |||
| 7 | 142.3, C | 128.8, C | 177.5, C | |||
| 8 | 139.7, C | 151.0, C | 159.2, C | |||
| 9 | 118.3, C | 116.3, C | 108.2, C | |||
| 10 | 144.8, C | 175.3, C | 182.9, C | |||
| 11 | 125.6, C | 178.9, C | 132.7, C | |||
| 12 | 65.3, CH | 5.49, d (10.6) | 111.1, CH | 6.38, s | 17.1, CH2 | 2.35, dd (16.8, 4.5) |
| 1.96, dd (16.7, 13.0) | ||||||
| 13 | 52.5, CH | 2.00, d (10.6) | 145.2, C | 48.5, CH | 1.49, dd (13.0, 4.2) | |
| 14 | 81.4, C | 81.2, C | 83.1, C | |||
| 15 | 38.3, CH2 | 2.04, m | 38.0, CH2 | 2.31, m | 38.4, CH2 | 2.11, m |
| 1.99, m | 2.05, m | 1.81, m | ||||
| 16 | 25.5, CH2 | 1.83, m | 24.7, CH2 | 1.80, m | 26.3, CH2 | 1.70, m |
| 1.64, m | 1.69, m | 1.56, m | ||||
| 17 | 84.2, CH | 3.26, m | 81.3, CH | 3.21, m | 85.4, CH | 3.09, dd (11.7, 3.7) |
| 18 | 36.9, C | 38.5, C | 36.8, C | |||
| 19 | 38.8, CH2 | 2.68, m | 35.0, CH2 | 2.13, m | 37.9, CH2 | 1.79, m |
| 1.49, m | 1.60, m | 1.19, m | ||||
| 20 | 21.8, CH2 | 1.69, m | 21.8, CH2 | 1.71, m | 22.3, CH2 | 1.58, m |
| 1.47, m | 1.58, m | 1.44, m | ||||
| 21 | 85.3, CH | 3.29, m | 84.7, CH | 3.19, m | 86.4, CH | 3.13, dd (11.9, 2.9) |
| 22 | 72.1, C | 72.0, C | 72.9, C | |||
| 23 | 26.2, CH3 | 1.20, s | 26.2, CH3 | 1.20, s | 25.6, CH3 | 1.07, s |
| 24 | 23.8, CH3 | 1.19, s | 24.0, CH3 | 1.19, s | 25.6, CH3 | 1.09, s |
| 25 | 12.6, CH3 | 1.11, s | 20.4, CH3 | 1.12, s | 12.7, CH3 | 0.84, s |
| 26 | 22.1, CH3 | 1.36, s | 26.9, CH3 | 1.53, s | 21.4, CH3 | 1.30, s |
| 27 | 13.2, CH3 | 1.44, d (7.1) | 9.9, CH3 | 2.25, s | 10.2, CH3 | 2.07, s |
| 28 | 15.6, CH3 | 0.76, d (6.6) | 19.8, CH3 | 1.27, d (7.0) | 20.2, CH3 | 1.15, d (6.6) |
| 29 | 152.2, CH | 8.82, s | ||||
| NH | 9.56, s | |||||
aMeasured in CD3OD, bMeasured in CDCl3
Fig. 2.
1H-1H COSY (blue bold lines) and HMBC (red arrows) correlations of compounds 1–6
Fig. 3.
ROESY correlations of compounds 1–6
Fig. 4.
Correlation plots of experimental and calculated 13C NMR for 1, 2, 4 and DP4 + results of all NMR data
Compound 2 was purified as a purple solid. The protonated molecule signal in the HRESIMS was used to calculate its chemical formula, which was C28H37NO5 (11 indices of hydrogen deficiency). The 1H NMR spectrum of 2 (Table 1) revealed indications for seven methyl groups [δH 0.85 (t, J = 7.4 Hz), 1.20 (s), 1.19 (s), 1.12 (s), 1.53 (s), 2.25 (s) and 1.27 (d, J = 7.0 Hz)], two oxymethine protons [δH 3.21 (m) and 3.19 (m)], as well as a number of aliphatic methylene multiplets. In connection with the DEPT experiment, the 13C NMR spectrum (Table 1) revealed 28 carbon resonances traceable to seven methyls, five methylenes, four methines (two oxygenated), and twelve quaternary carbons (three oxygenated carbons and two carbonyls). The 1H and 13C NMR data of 2 were structurally similar to those of cochlioquinone G [17] except for the absence of a hydroxyl group at C-12 and the presence of an additional double bond at δC 111.1 (C-12) and 145.2 (C-13). This hypothesiswas validated by HMBC correlations from H-12 (δH 6.38) to C-10 (δC 175.3), C-9 (δC 116.3), C-8 (δC 151.0) and C-14 (δC 81.2) (Fig. 2). The ROESY correlations of H-21/H-17 indicated that H-21 and H-17 were on the same face and were given as α-orientation (Fig. 3). The correlations of CH3-25 and CH3-26 established the β-orientation of H3-25 and H3-26, which was similar to those of cochlioquinone G. Similar to 1, the absolute configuration of C-3 was calculated utilizing chemical shifts of C-2 (δC 29.8) and the quantum chemical calculations of the NMR data as well as DP4 + analysis (Fig. 4 and Additional file 1: Fig. S79). Therefore, the absolute configuration of 2 was defined as (3S,14R,17R,18R,21R)-2.
Compound 3 was purified as a yellow oil. The protonated molecule signal in the HRESIMS was used to calculate its chemical formula, which was C28H39NO5 (10 indices of hydrogen deficiency). The NMR data (Table 1) showed that compound 3 was comparable to compound 2 except for the lack of a double bond group at C-13 (δC 145.2) and C-12 (δC 111.1) and the presence of two alkyl carbons of C-13 (δC 48.5) and C-12 (δC 17.1). This difference indicated that the double bond of C-13 and C-12 were replaced by a single bond, which was confirmed by HMBC correlations from H-12 (δH 2.35) to C-10 (δC 182.9), C-8 (δC 159.2) and C-14 (δC 83.1) and 1H–1H COSY correlations of H-13/H-12 (Fig. 2). Based on the ROESY profile (Fig. 3) and its likely biosynthesis origin from 2, the conformation of 3 was determined as the 3S,13R,14R,17R,18R,21R conformation, which should be the same as 2.
Compound 4 was purified as a colorless powder. The protonated molecule signal in the HRESIMS was used to calculate its chemical formula, which was C27H40O6 (8 indices of hydrogen deficiency). Its 13C NMR spectra indicated 27 signals generated by six methyl carbons, seven sp3 methylene carbons, four sp3 tertiary carbons, two sp2 methine carbons, two sp3 quaternary carbons, four sp2 nonprotonated carbons and two carbonyl carbons. The 1H and 13C NMR data of 4 (Table 2) were similar to those of terpestacin (11) [20]. The obvious differences disclosed were that the double bond between C-12 and C-13 was absent and two more oxygenated resonances (δC 65.1 and 63.5) occurred, suggesting that the double bond in 11 is oxidized to form an epoxy ring in compound 4, which was confirmed by the 1H–1H COSY correlations of H-15/H-14/H-13 and HMBC correlations from H-13 to C-22, C-15 and C-11 (Fig. 2). ROESY correlations between H-3/H-5, H-20/H-2, H-7/H-9 and H-21/H-6 show that the two double bonds in 4 were E-configured. While the ROESY correlation between H-15/H-23 implied that they were on the identical side and assigned as β-orientation, the correlation between H-19/H-13, H-19/H-14b, H-14b/H-22, suggested that they were assigned as α-orientation (Fig. 3). Furthermore, quantum chemical calculations of the nuclear magnetic resonance data (qccNMR) of two diastereoisomers, (12S,13S)-4 and (12R,13R)-4, were undertaken to identify the configuration of the epoxy ring on C-12 and C-13. The two epimers were rigorously conformationally screened, and NMR chemical shifts were estimated in methanol using the mPW1PW91/6–31 + G(d,p)//M06-2X/def2-SVP level of theory and the PCM solvent model. With a DP4 + probability of 100%, the DP4 + analysis also revealed (12R,13R)-4 as the most plausible structure for 4. (all data) (Fig. 4), which was compatible with the ROESY study results presented above. Therefore, the absolute configuration of 4 was specified as (1S,11S,12R,13R,15R,23S)-4.
Table 2.
1H (600 MHz) and 13C (150 MHz) NMR data of compounds 4–6
| No. | 4a | 5b | 6a | |||
|---|---|---|---|---|---|---|
| δC, type | δH (J in Hz) | δC, type | δH (J in Hz) | δC, type | δH (J in Hz) | |
| 1 | 50.0, C | 49.0, C | 58.5, CH | 2.60, m | ||
| 2 | 39.2, CH2 | 2.36, m | 37.9, CH2 | 2.40, m | 164.4, C | |
| 1.80, m | 1.86, m | |||||
| 3 | 122.3, CH | 5.37, t (8.4) | 120.7, CH | 5.29, t (8.2) | 42.2, C | |
| 4 | 139.8, C | 138.9, C | 53.0, CH2 | 2.07, m | ||
| 1.65, m | ||||||
| 5 | 41.0, CH2 | 2.25, m | 39.9, CH2 | 2.21, m | 67.2, CH | 3.87, m |
| 2.07, m | 2.05, m | |||||
| 6 | 24.8, CH2 | 2.28, m | 23.8, CH2 | 2.21, m | 47.1, CH2 | 1.98, m |
| 2.21, m | 1.21, m | |||||
| 7 | 124.7, CH | 5.11, t (6.0) | 123.8, CH | 5.03, t (6.5) | 58.8, CH | 1.81, m |
| 8 | 134.9, C | 133.8, C | 29.7, CH3 | 0.96, s | ||
| 9 | 34.8, CH2 | 2.19, m | 34.1, CH2 | 2.21, m | 32.5, C | |
| 1.99, m | 1.94, m | |||||
| 10 | 31.6, CH2 | 1.76, m | 29.7, CH2 | 1.85, m | 31.6, CH3 | 0.95, s |
| 1.65, m | 1.62, m | |||||
| 11 | 76.6, CH | 3.05, t (7.0) | 75.9, CH | 3.11, dd (8.2, 6.1) | 30.4, CH3 | 1.10, s |
| 12 | 65.1, C | 64.6, C | 103.7, CH2 | 4.96, s | ||
| 4.74, s | ||||||
| 13 | 63.5, CH | 2.86, dd (7.4, 2.2) | 63.8, CH | 2.92, dd (7.5, 2.3) | 46.2, CH | 2.09, m |
| 14 | 29.6, CH2 | 1.88, m | 28.0, CH2 | 1.88, m | 38.7, CH2 | 2.21, m |
| 1.51, m | 1.51, m | 1.19, m | ||||
| 15 | 49.1, CH | 2.79, dd (8.1, 4.2) | 48.3, CH | 2.81, dd (6.9, 4.7) | 75.0, CH | 3.66, m |
| 16 | 149.4, C | 149.2, C | ||||
| 17 | 149.6, C | 146.8, C | ||||
| 18 | 209.0, C | 207.3, C | ||||
| 19 | 18.6, CH3 | 1.03, s | 18.5, CH3 | 1.05, s | ||
| 20 | 15.8, CH3 | 1.68, s | 15.9, CH3 | 1.65, s | ||
| 21 | 16.4, CH3 | 1.63, s | 16.1, CH3 | 1.61, s | ||
| 22 | 11.0, CH3 | 1.24, s | 10.9, CH3 | 1.27, s | ||
| 23 | 34.8, CH | 2.90, m | 36.7, CH | 2.78, m | ||
| 24 | 67.5, CH2 | 4.29, m | 66.3, CH2 | 3.87, m | ||
| 3.80, m | ||||||
| 25 | 172.8, C | 14.5, CH3 | 1.27, d (1.3) | |||
| 26 | 20.8, CH3 | 2.00, s | ||||
| 27 | 14.8, CH3 | 1.28, d (7.0) | ||||
aMeasured in CD3OD, bMeasured in CDCl3
Compound 5 was purified as a colorless powder. The protonated molecule signal in the HRESIMS was used to calculate its chemical formula, which was C25H38O5 (7 indices of hydrogen deficiency). Its 13C NMR spectra revealed 25 signals from five methyl carbons, seven sp3 methylene carbons, four sp3 tertiary carbons, two sp2 methine carbons, two sp3 quaternary carbons, four sp2 nonprotonated carbons and a carbonyl carbon. The NMR spectra of 5 indicated that it is closely linked to 4, except that 4 lacks an acetyl group and has an additional hydroxyl group at C-24, which is corroborated by the 42 Da drop in molecular weight of 5 when compared to 4. Based on ROESY profile (Fig. 3) and its potential biosynthetic origin from 4, the configuration of 5 would be equivalent to 4 for (1S,11S,12R,13R,15R,23S)-5.
Compound 6 was purified as a colorless powder. The protonated molecule signal in the HRESIMS was used to calculate its chemical formula, which was C15H24O2 (4 indices of hydrogen deficiency). The 1H and 13C NMR spectra (Table 2) revealed 15 signals from three methyl carbons, three sp3 methylene carbons, one sp2 methylene carbon, five sp3 tertiary carbon, two sp3 quaternary carbons, and one sp2 nonprotonated carbon. According to the preceding data, the structural properties of 6 were comparable to those of longi-β-nozigiku alcohol [21], with the exception of an extra hydroxyl group in 6. Chemical shifts at the C-5 (δC 67.2) level have increased relative, together with the critical HMBC correlation from H-5 (δH 3.87) to C-3 and C-9, suggesting the hydroxyl group was annexed to C-5 (Fig. 2). The ROESY correlations of H-15/H-7and H-13/H-7 indicated that H-15, H-13 and H-7 are on the identical side and belong to the α-orientation (Fig. 3). The correlations of H-1/H-10 determined the β-orientation of H-1. Meanwhile, the correlations of H-5/H-11, H-11/H-13 and H-8/H-5 indicated that H-13, H-11, H-8 and H-5 are on the identical side and belong to the α-orientation (Fig. 3). Hence, the hydroxyl groups that exist at C-5 is β-configuration. The absolute configurations of 6 was determined by comparing the experimental ECD spectra with calculated ECD spectra (Fig. 5). Therefore, the absolute configuration of 6 was defined as (1R,3R,5R,7S,13S,15R)-6.
Fig. 5.

Experimental and calculated ECD curves of compound 6
Eleven known compounds were identified as isocochlioquinone A (7) [11], cochlioquinone N (8) [22], stemphone (9) [23], (–)-terpestacin (10) [24], fusaproliferin (11) [20], cis-sativenediol (12) [25], helminthosporic acid (13), cochliobolin B (14) and cochliobolin A (15) [26], helminthosporol (16) [27] and bipolarisorokin H (17) [28] respectively, based on spectroscopic data comparisons with reported values.
Since terpenoids are known to exhibit a variety of biological activities, the four sesterterpenes (4, 5, 10 and 11) were tested for their antibacterial, antifungal and cytotoxic properties, and six meroterpenoids (1–3, 7–9) were evaluated for their antifungal activities. The antibacterial activity was evaluated against the Escherichia coli, Staphylococcus aureus subsp. Aureus, Salmonella enterica subsp. Enterica and Pseudomonas aeruginosa [29], but all tested compounds did not show any promising activity up to the highest tested concentration of 100 µM (Additional file 1: Table S7). Likewise, no cytotoxic activity against the human cancer cell lines (HL-60, A549, SMMC-7721, MDA-MB-231 and SW480) could be detected (at 40 μM) (Additional file 1: Table S8). The antifungal activity was evaluated against the Epidermophyton floccosum, Trichophyton rubrum, Microsporum gypseum and Candida albicans. The compounds 7, 9, and 10 had good antifungal activity against E. floccosum at a concentration of 100 µM, and compounds 1, 4, 5 and 10 exhibited moderate or weak antifungal activity against M. gypseum (Table 3).
Table 3.
Inhibitory effect of compounds on four strains of fungi
| Compound | Density (µM) | Inhibition rate (%) | |||
|---|---|---|---|---|---|
| C. albicans | E. floccosum | T. rubrum | M. gypseum | ||
| Amphotericin B | 0.5 | 100.092 ± 0.054 | |||
| Terbinafine hydrochloride | 3 | 102.044 ± 0.354 | 101.872 ± 0 | ||
| 15 | 101.804 ± 0.773 | ||||
| 1 | 100 | − 1.701 ± 0.586 | 65.06 ± 0 | 45.771 ± 0.547 | 51.07 ± 5.954 |
| 2 | 100 | 6.326 ± 0.236 | 42.382 ± 0.512 | 5.128 ± 0.241 | − 16.246 ± 1.052 |
| 3 | 100 | − 18.526 ± 0.456 | 46.977 ± 2.168 | − 21.855 ± 3.279 | − 20.503 ± 3.681 |
| 4 | 100 | 12.075 ± 3.379 | − 1.514 ± 2.471 | − 59.348 ± 2.767 | 53.108 ± 0.354 |
| 5 | 100 | 6.969 ± 0.265 | 8.094 ± 0.412 | − 95.87 ± 0.923 | 55.981 ± 1.237 |
| 7 | 100 | − 8.244 ± 0.738 | 81.611 ± 2.601 | − 3.693 ± 2.733 | 24.967 ± 8.383 |
| 8 | 100 | − 7.815 ± 0.786 | 18.78 ± 0.434 | − 0.215 ± 3.279 | 18.418 ± 24.981 |
| 9 | 100 | − 5.977 ± 2.731 | 94.484 ± 0.867 | 61.228 ± 0.547 | 38.439 ± 20.418 |
| 10 | 100 | 12.309 ± 0.133 | 99.806 ± 1.165 | − 46.957 ± 0 | 60.354 ± 1.767 |
| 11 | 100 | − 3.104 ± 2.187 | − 3.844 ± 1.647 | 19.566 ± 1.845 | 37.741 ± 0.177 |
Conclusions
In conclusion, seventeen terpenoids, including six undescribed compounds, were identified from the endophytic fungus B. eleusines. Among these isolates, no compounds exhibited antibacterial and cytotoxic activities. However, the compounds 7, 9 and 10 had significant antifungal activity against E. floccosum. Our initial findings indicate that the endophytic fungus B. eleusines is a plentiful supply of different and bioactive terpenoids.
General experimental procedures
A Bruker spectrometer (Bruker, Germany, model AM600) was used to obtain 1D and 2D spectra. A Q Exactive HF mass spectrometer (Thermo Fisher Scientific, USA) was used to collect HRESIMS date. Applied Circular dichroism spectrometer (Chirascan, New Haven, USA) was used to record CD spectra. Column chromatography (CC) was performed on silica gel (Qingdao Marine Chemical Ltd., Qingdao, China), RP-18 gel (Fuji Silysia Chemical Ltd., Japan), and Sephadex LH-20 (Pharmacia Fine Chemical Co., Ltd., Sweden) [30]. Semipreparative HPLC experiments were carried out on an Agilent 1260 HPLC with an Agilent Zorbax SB-C18 column (5 μm, 250 × 9.8 mm). Thin layer chromatography (GF 254) was used to monitor fractions, and spots were seen by heating silica gel plates coated with vanillin and 10% H2SO4 in ethanol.
Culture and fermentation of fungal material
This fungus was identified by PCR amplification using fungal 18S universal primers ITS1 and ITS4. The sequenced 18S rDNA ITS sequences were subjected to homology sequence alignment analysis, which, using BLAST, showed 99% maximum similarity to Bipolaris eleusines with the gene bank registration number (KY909768.1). Therefore, it was identified as B. eleusines, which was preserved in South-Central Minzu University, China. The strains were inoculated into PDA agar medium and incubated for 3–5 days at a constant temperature of 25 °C. The medium was then cut into several small pieces and placed into a solid wheat medium (50 g wheat and 50 mL water in 500 mL culture flasks, autoclaved at 120 °C for 30 min, for a total of 212 flasks) and fermented at 25 °C for 28 days.
Extraction and isolation
The wheat medium was pounded and extracted five times with EtOAc to yield 167 g of raw extract. The EtOAc extract was subjected to silica gel CC and eluted with a gradient of CH2Cl2–MeOH (100:0–0:100, v/v) to obtain six fractions (A–F). Fraction D (31.6 g) was subjected to C18 MPLC using MeOH–H2O (30:70–100:0, v/v), yielding ten subfractions (D1–D10). Fraction D5 (1.9 g) was divided by CC over silica gel and eluted in PE with a gradient of increasing acetone concentrations (30–100) to provide six fractions (D5-1–D5-6). Fraction D5-5 (613.9 mg) was divided by using preparative HPLC (gradient elution with MeOH–H2O, 18:82–40:60) to get 11 (3.2 mg, tR = 12.7 min) and 12 (2.1 mg, tR = 13.5 min). The Fraction D9 (903.5 mg) was separated into six subfractions D9-1–D9-6 by column chromatography (Sephadex LH-20, MeOH). Fraction D9-3 (113.6 mg) was separated by using preparative HPLC with a gradient of MeCN–H2O (50:50–60:40, v/v) to obtain 8 (4.3 mg, tR = 20.5 min), 9 (1.2 mg, tR = 24.6 min) and 10 (2.2 mg, tR = 25.2 min). Fraction D9-4 (160.1 mg) was separated by using preparative HPLC with a gradient of MeCN–H2O (40:60–60:40, v/v) to get 7 (3.5 mg, tR = 12.1 min) and 16 (2.1 mg, tR = 14.5 min). Fraction D9-6 (106.2 mg) was separated by Sephadex LH-20 (MeOH) to give four subfractions D9-6–1–D9-6–4 and then purified by usingpreparative HPLC with MeCN–H2O (50:50–60:40, v/v) to obtain 2 (12.2 mg, tR = 32.6 min), 14 (4.5 mg, tR = 34.2 min) and 13 (1.1 mg, tR = 35.3 min). Fraction E (33.2 g) was separated by C18 MPLC using MeOH–H2O (10:90–100:0, v/v), yielding eight subfractions (E1–E8). The fraction E4 (3.4 g) was isolated by using Sephadex LH-20 and eluted with MeOH to yield five subdivisions E4-1–E4-5. Fraction E4-2 (532.6 mg) was divided by C18 MPLC with MeOH–H2O (60:40–75:25, v/v) to obtain 3 (5.2 mg, tR = 18.2 min) and 15 (13.5 mg, tR = 24.5 min). Fraction E4-5 (267.9 mg) was separated by using preparative HPLC with MeOH–H2O (65:35–80:20, v/v) to afford 6 (20.6 mg, tR = 22.4 min) and 4 (15.7 mg, tR = 26.8 min). Fraction E8 (7.4 g) was subjected to CC over silica gel with a gradient elution of PE-acetone (30:1–30:60, v/v) and then separated using a preparative C18 HPLC column with MeCN–H2O (45:55–60:40, v/v) to afford 1 (4.1 mg, tR = 26.4 min), 5 (20.6 mg, tR = 34.3 min) and 17 (6.2 mg, tR = 36.4 min).
Bipolariterpene A (1)
Colorless solid; mp 247–252 ℃; UV (CH3OH) λmax (log ε) = 235 (3.61); IR (KBr): 3414, 2970, 2939, 2874, 1713, 1655, 1458, 1431, 1381, 1342, 1308, 1246, 1146, 1092, 1026, 833 cm−1; +361 (c 0.5, CH3OH); 1H NMR and 13C NMR (CDCl3) data are shown in Table 1; HRESIMS m/z 532.27271 [M + H] + (calcd for C29H42NO6S, 532.27274).
Bipolariterpene B (2)
Yellow oil; UV (CH3OH) λmax (log ε) = 210 (2.49), 225 (2.49), 275 (2.57); IR (KBr): 3248, 2963, 2936, 1666, 1632, 1578, 1493, 1443, 1377, 1304, 1269, 1207, 1138, 1096, 1053, 1022, 957 cm−1; +315 (c 0.5, CH3OH); 1H NMR and 13C NMR (CDCl3) data are shown in Table 1; HRESIMS m/z 490.25650 [M + Na] + (calcd for C28H37NNaO5, 490.25639).
Bipolariterpene C (3)
Purple solid; mp 259–264 ℃; UV (CH3OH) λmax (log ε) = 245 (2.81); IR (KBr): 3453, 2959, 2939, 2874, 2862, 1666, 1647, 1628, 1570, 1516, 1458, 1381, 1334, 1227, 1207, 1142, 1092, 1022 cm − 1; +216 (c 0.1, CH3OH); 1H NMR and 13C NMR (methanol-d4) data are shown in Table 1; HRESIMS m/z 470.28995 [M + H] + (calcd for C28H40NO5, 470.29010).
Bipolariterpene D (4)
Colorless powder; UV (CH3OH) λmax (log ε) = 205 (2.69), 260 (2.55); IR (KBr): 3387, 2974, 2939, 1740, 1709, 1655, 1458, 1373, 1238, 1038 cm−1; +14 (c 0.6, CH3OH); 1H NMR and 13C NMR (methanol-d4) data are shown in Table 2; HRESIMS m/z 483.27190 [M + Na]+ (calcd for C27H40NaO6, 483.27171).
Bipolariterpene E (5)
Colorless powder; UV (CH3OH) λmax (log ε) = 265 (1.59); IR (KBr): 3375, 2970, 2936, 1697, 1651, 1450, 1408, 1389, 1312, 1142, 1030, 941, 856 cm−1; +19 (c 0.5, CH3OH); 1H NMR and 13C NMR (CDCl3) data are shown in Table 2; HRESIMS m/z 441.26097 [M + Na]+ (calcd for C25H38NaO5, 441.26115).
Bipolariterpene F (6)
Colorless powder; UV (CH3OH) λmax (log ε) = 210 (2.56); IR (KBr): 3314, 2955, 1659, 1597, 1450, 1346, 1177, 1130, 1042, 1003, 949, 880 cm−1; -2 (c 0.5, CH3OH); 1H NMR and 13C NMR (methanol-d4) data are shown in Table 2; HRESIMS m/z 237.18486 [M + H]+ (calcd for C15H25O2, 237.18491).
Quantum chemical calculations
13C NMR calculation
The NMR chemical shift calculations were carried out in Gaussian 16 using density functional theory (DFT) [31]. Spartan’14 software was used to conduct the preliminary conformational distribution search. GaussView 6.0 was used to view conformational structures and modify computation input files for calculation. At the M062X/def2svp level, all ground-state geometries were optimized, and the stable conformations obtained at that level were then used in magnetic shielding constants at the mpw1pw91/6–31 + g(d,p) level. GaussView 6.0 was used to display the calculated chemical shift of each atom in each conformer, and the final chemical shift of each atom was calculated from the Boltzmann distribution of each conformer. The stereochemistry was assigned using the DP4 + probability analysis of calculated and experimental chemical shifts.
ECD calculations
The absolute conformations of the compounds were determined using Gaussian 16 software. Briefly, the relative conformations of the compounds were first determined by ROESY spectroscopy, followed by a preliminary conformational analysis based on Spartan’14software. The obtained conformations were optimized at the M062X/def2svp level of density functional theory (TDDFT), and then ECD calculations were performed by M062X/def2svp. The ECD curves were generated by Origin software.
Antifungal assay
The endophytic fungus used in this assay was Bipolaris eleusines, and the samples to be tested were diluted in 96-well plates, and the fungal solution was added to each well. C. albicans was nurtured at 37 °C for 24 h, and Filamentous fungi were nurtured at 25 °C for 5 days, and the absorbance value at 625 nm was measured by an enzyme marker. The experiment was set up with a medium blank control, a fungal control [32], and positive drug controls for amphotericin B and terbinafine hydrochloride.
Antibacterial assay
The samples were evaluated for their antibacterial activity against Escherichia coli, Staphylococcus aureus subsp. Aureus, Salmonella enterica subsp. Enterica and Pseudomonas aeruginosa. Dissolve the compounds to be tested to a concentration range of 100 μM and add it to a 96-well culture plate. Each well received a bacteria solution until the final concentration reached 5 × 105 CFU/ml. It was then cultivated at 27 ℃ for 24 h, and the inhibition rate was determined by the microplate reader at OD 600 nm. The medium blank control was used in the experiment [12]. Sodium penicillin G and ceftazidime were used as the positive control.
Cytotoxicity assay
Five human cancer cell lines including HL-60 (promyelocytic leukemia), A549 (lung epithelial cancer), SMMC-7721 (liver cancer), MDA-MB-231 (breast cancer), and SW480 (colon cancer) were used for cytotoxicity assays by MTS method [12]. In a word, cells were cultured in DMEM media supplemented with 10% fetal bovine serum before being injected in 96-well culture plates and treated with different concentrations of compounds. After 24 h, each well received 20 μL of MTS, and the OD at 492 nm was determined using a microplate reader.
Supplementary Information
Additional file 1: Fig. S1. 1H NMR spectrum of 1. Fig. S2. 13C NMR spectrum of 1. Fig. S3. HSQC spectrum of 1. Fig. S4. HMBC spectrum of 1. Fig. S5. 1H-1H COSY spectrum of 1. Fig. S6. ROESY spectrum of 1. Fig. S7. HRESIMS spectrum of 1. Fig. S8. IR spectrum of 1. Fig. S9. UV spectrum of 1. Fig. S10. 1H NMR spectrum of 2. Fig. S11. 13C NMR spectrum of 2. Fig. S12. HSQC spectrum of 2. Fig. S13. HMBC spectrum of 2. Fig. S14. 1H-1H COSY spectrum of 2. Fig. S15. ROESY spectrum of 2. Fig. S16. HRESIMS spectrum of 2. Fig. S17. IR spectrum of 2. Fig. S18. UV spectrum of 2. Fig. S19. 1H NMR spectrum of 3. Fig. S20. 13C NMR spectrum of 3. Fig. S21. HSQC spectrum of 3. Fig. S22. HMBC spectrum of 3. Fig. S23. 1H-1H COSY spectrum of 3. Fig. S24. ROESY spectrum of 3. Fig. S25. HRESIMS spectrum of 3. Fig. S26. IR spectrum of 3. Fig. S27. UV spectrum of 3. Fig. S28. 1H NMR spectrum of 4. Fig. S29. 13C NMR spectrum of 4. Fig. S30. HSQC spectrum of 4. Fig. S31 HMBC spectrum of 4. Fig. S32. 1H-1H COSY spectrum of 4. Fig. S33. ROESY spectrum of 4. Fig. S34. HRESIMS spectrum of 4. Fig. S35. IR spectrum of 4. Fig. S36. UV spectrum of 4. Fig. S37. 1H NMR spectrum of 5. Fig. S38. 13C NMR spectrum of 5. Fig. S39. HSQC spectrum of 5. Fig. S40. HMBC spectrum of 5. Fig. S41. 1H-1H COSY spectrum of 5. Fig. S42. ROESY spectrum of 5. Fig. S43. HRESIMS spectrum of 5. Fig. S44. IR spectrum of 5. Fig. S45. UV spectrum of 5. Fig. S46. 1H NMR spectrum of 6. Fig. S47. 13C NMR spectrum of 6. Fig. S48. HSQC spectrum of 6. Fig. S49. HMBC spectrum of 6. Fig. S50. 1H-1H COSY spectrum of 6. Fig. S51. ROESY spectrum of 6. Fig. S52. HRESIMS spectrum of 6. Fig. S53. IR spectrum of 6. Fig. S54. UV spectrum of 6. Fig. S55. 1H NMR spectrum of 7. Fig. S56. 13C NMR spectrum of 7. Fig. S57. 1H NMR spectrum of 8. Fig. S58. 13C NMR spectrum of 8. Fig. S59. 1H NMR spectrum of 9. Fig. S60. 13C NMR spectrum of 9. Fig. S61. 1H NMR spectrum of 10. Fig. S62. 13C NMR spectrum of 10. Fig. S63. 1H NMR spectrum of 11. Fig. S64. 13C NMR spectrum of 11. Fig. S65. 1H NMR spectrum of 12. Fig. S66. 13C NMR spectrum of 12. Fig. S67. 1H NMR spectrum of 13. Fig. S68. 13C NMR spectrum of 13. Fig. S69. 1H NMR spectrum of 14. Fig. S70. 13C NMR spectrum of 14. Fig. S71. 1H NMR spectrum of 15. Fig. S72. 13C NMR spectrum of 15. Fig. S73. 1H NMR spectrum of 16. Fig. S74. 13C NMR spectrum of 16. Fig. S75. 1H NMR spectrum of 17. Fig. S76 13C NMR spectrum of 17. Fig. S77. Correlations between calculated and experimental 13C NMR chemical shifts of 1A and 1B. Fig. S78. DP4 + analysis results of 1. Table S1. Energy analysis for conformers of 1Aa ~ 1Ae at mpw1pw91/6–31 + g(d,p) level in the gas phase. Table S2. Cartesian coordinates for the low-energy optimized conformers of 1A at M062X/def2svp level. Fig. S79. Correlations between calculated and experimental 13C NMR chemical shifts of 2A and 2B. Fig. S80. DP4 + analysis results of 2. Table S3. Energy analysis for conformers of 2Aa ~ 2Ae at mpw1pw91/6–31 + g(d,p) level in the gas phase. Table S4. Cartesian coordinates for the low-energy optimized conformers of 2A at M062X/def2svp level. Fig. S81. Correlations between calculated and experimental.13C NMR chemical shifts of 4A and 4B. Fig. S82. DP4 + analysis results of 4 Table S5. Energy analysis for conformers of 4Aa ~ 4Ae at mpw1pw91/6–31 + g(d,p) level in the gas phase Table S6. Cartesian coordinates for the low-energy optimized conformers of 4A at M062X/def2svp level. Table S7. Inhibitory effect of compounds on four strains of bacteria. Table S8. Inhibitory effect of compounds on five strains of Cytotoxicity.
Acknowledgements
This work was financially supported by the National Natural Science Foundation of China (32000011, 82204239), Hubei Provincial Natural Science Foundation of China (2022CFB462), the Fund of State Key Laboratory of Phytochemistry and Plant Resources in West China (P2022-KF03), the Fundamental Research Funds for the Central Universities, South-Central MinZu University (CZY23024). The authors thank the Bioactivity Screening Center, Kunming Institute of Botany, Chinese Academy of Sciences, for screening the bioactivity of the compounds.
Author contributions
H.-L. A. isolated and provided the fungus. Y.-Z. F. contributed to the extraction, isolation, and identification of the samples. C. T. was responsible for the evaluation of cytotoxic activity. S.-Y. T., Q. L. and F. X. contributed to the extraction and isolation of the samples. Y.-Z. F. and B.-B. S. performed chemical calculation and wrote the paper. H.-L. A. and J.-K. L. designed experiments. All authors reviewed the manuscript.
Funding
This work was financially supported by the National Natural Science Foundation of China (32000011, 82204239), Hubei Provincial Natural Science Foundation of China (2022CFB462), the Fund of State Key Laboratory of Phytochemistry and Plant Resources in West China (P2022-KF03), the Fundamental Research Funds for the Central Universities, South-Central MinZu University (CZY23024).
Availability of data and materials
All data generated and analyzed during this study are included in this published article and its Additional file.
Declarations
Competing interests
The authors declare that they have no known competing financial interests or personal relationships that could have appeared to influence the work reported in this paper.
Footnotes
Publisher's Note
Springer Nature remains neutral with regard to jurisdictional claims in published maps and institutional affiliations.
Contributor Information
Bao-Bao Shi, Email: shibb0505@163.com.
Hong-Lian Ai, Email: aihonglian@mail.scuec.edu.cn.
Ji-Kai Liu, Email: liujikai@mail.scuec.edu.cn.
References
- 1.Rudolf JD, Alsup TA, Xu B, Li Z. Bacterial terpenome. Nat Prod Rep. 2021;38:905–980. doi: 10.1039/D0NP00066C. [DOI] [PMC free article] [PubMed] [Google Scholar]
- 2.Hillier SG, Lathe R. Terpenes, hormones and life: isoprene rule revisited. J Endocrinol. 2019;242:R9–R22. doi: 10.1530/JOE-19-0084. [DOI] [PubMed] [Google Scholar]
- 3.Rudolf JD, Chang CY. Terpene synthases in disguise: enzymology, structure, and opportunities of non-canonical terpene synthases. Nat Prod Rep. 2020;37:425–463. doi: 10.1039/C9NP00051H. [DOI] [PMC free article] [PubMed] [Google Scholar]
- 4.Silva BIM, Nascimento EA, Silva CJ, Silva TG, Aguiar JS. Anticancer activity of monoterpenes: a systematic review. Mol Biol Rep. 2021;48:5775–5785. doi: 10.1007/s11033-021-06578-5. [DOI] [PubMed] [Google Scholar]
- 5.Hoang LS, Tran MH, Lee JS, Ngo QMT, Woo MH, Min BS. Inflammatory inhibitory activity of sesquiterpenoids from Atractylodes macrocephala rhizomes. Chem Pharm Bull. 2016;64:507–511. doi: 10.1248/cpb.c15-00805. [DOI] [PubMed] [Google Scholar]
- 6.Vo QV, Tam NM, Hieu LT, Van Bay M, Thong NM, Le Huyen T, Hoa NT, Mechler A. The antioxidant activity of natural diterpenes: theoretical insights. RSC Adv. 2020;10:14937–14943. doi: 10.1039/D0RA02681F. [DOI] [PMC free article] [PubMed] [Google Scholar]
- 7.Ortega HE, Torres-Mendoza D, Caballero EZ, Cubilla-Rios L. Structurally uncommon secondary metabolites derived from endophytic fungi. J Fungi. 2021;7:570. doi: 10.3390/jof7070570. [DOI] [PMC free article] [PubMed] [Google Scholar]
- 8.Amirzakariya BZ, Shakeri A. Bioactive terpenoids derived from plant endophytic fungi: an updated review (2011–2020) Phytochemistry. 2022;197:113130. doi: 10.1016/j.phytochem.2022.113130. [DOI] [PubMed] [Google Scholar]
- 9.Manamgoda DS, Rossman AY, Castlebury LA, Crous PW, Madrid H, Chukeatirote E, Hyde KD. The genus Bipolaris. Stud Mycol. 2014;79:221–288. doi: 10.1016/j.simyco.2014.10.002. [DOI] [PMC free article] [PubMed] [Google Scholar]
- 10.Takemoto D, Shibata Y, Ojika M, Mizuno Y, Imano S, Ohtsu M, Sato I, Chiba S, Kawakita K, Rin S, Camagna M. Resistance to Phytophthora infestans: exploring genes required for disease resistance in Solanaceae plants. J Gen Plant Pathol. 2018;84:312–320. doi: 10.1007/s10327-018-0801-8. [DOI] [Google Scholar]
- 11.Miyagawa H, Nagai S, Tsurushima T, Sato M, Ueno T, Fukami H. Phytotoxins produced by the plant pathogenic fungus bipolar is bicolor El-1. Biosci Biotechnol Biochem. 1994;58:1143–1145. doi: 10.1271/bbb.58.1143. [DOI] [Google Scholar]
- 12.Yu JJ, Wei WK, Zhang Y, Cox RJ, He J, Liu JK, Feng T. Terpenoids from Kiwi endophytic fungus Bipolaris sp. and their antibacterial activity against Pseudomonas syringae pv. actinidiae. Front Chem. 2022;10:1–12. doi: 10.3389/fchem.2022.990734. [DOI] [PMC free article] [PubMed] [Google Scholar]
- 13.Feng L, Wang XJ, Li L, Zhang AX, Shang RR, Tan NH, Wang Z. Identification of meroterpenoids from Bipolaris victoriae S27 and their potential activity against tumor metastasis and inhibition of the NF-κB signaling pathway. Phytochemistry. 2022;200:113180. doi: 10.1016/j.phytochem.2022.113180. [DOI] [PubMed] [Google Scholar]
- 14.Ai HL, Shi BB, Li W, He J, Li ZH, Feng T, Liu JK. Bipolarithizole A, an antifungal phenylthiazole-sativene merosesquiterpenoid from the potato endophytic fungus Bipolaris eleusines. Org Chem Front. 2022;9:1814–1819. doi: 10.1039/D1QO01887F. [DOI] [Google Scholar]
- 15.He J, Yang MS, Wang WX, Li ZH, Elkhateeb WAM, Wen TC, Ai HL, Feng T. Anti-phytopathogenic sesquiterpenoid-xanthone adducts from potato endophytic fungus Bipolaris eleusines. RSC Adv. 2019;9:128–131. doi: 10.1039/C8RA09861A. [DOI] [PMC free article] [PubMed] [Google Scholar]
- 16.He J, Li ZH, Ai HL, Feng T, Liu JK. Anti-bacterial chromones from cultures of the endophytic fungus Bipolaris eleusines. Nat Prod Res. 2019;33:3515–3520. doi: 10.1080/14786419.2018.1486313. [DOI] [PubMed] [Google Scholar]
- 17.Han JY, Zhang JY, Song ZJ, Zhu GL, Liu MM, Dai HQ, Hsiang T, Liu XT, Zhang LX, Quinn RJ, Feng Y. Genome-based mining of new antimicrobial meroterpenoids from the phytopathogenic fungus Bipolaris sorokiniana strain 11134. Appl Microbiol Biotechnol. 2020;104:3835–3846. doi: 10.1007/s00253-020-10522-1. [DOI] [PubMed] [Google Scholar]
- 18.Liu M, Gu L, Shen L, Zhang X, Lin S, Ye Y, Wang J, Hu Z, Zhang Y. Bipolaquinones A-J, immunosuppressive meroterpenoids from a soil-derived Bipolaris zeicola. J Nat Prod. 2021;84:2427–2436. doi: 10.1021/acs.jnatprod.1c00327. [DOI] [PubMed] [Google Scholar]
- 19.Zhang X, Wang TT, Xu QL, Xiong Y, Zhang L, Han H, Xu K, Guo WJ, Xu Q, Tan RX, Ge HM. Genome mining and comparative biosynthesis of meroterpenoids from two phylogenetically distinct fungi. Angew Chem Int Ed. 2018;57:8184–8188. doi: 10.1002/anie.201804317. [DOI] [PubMed] [Google Scholar]
- 20.Santini A, Ritieni A, Fogliano V, Randazzo G, Mannina L, Logrieco A, Benedetti E. Structure and absolute stereochemistry of fusaproliferin, a toxic metabolite from Fusarium proliferatum. J Nat Prod. 1996;59:109–112. doi: 10.1021/np960023k. [DOI] [PubMed] [Google Scholar]
- 21.Mukai A, Takahashi K, Ashitani T. Natural autoxidation of longifolene and anti-termite activities of the products. J Wood Sci. 2017;63:360–368. doi: 10.1007/s10086-017-1637-0. [DOI] [Google Scholar]
- 22.Long Y, Tang T, Wang LY, He B, Gao K. Absolute configuration and biological activities of meroterpenoids from an endophytic fungus of Lycium barbarum. J Nat Prod. 2019;82:2229–2237. doi: 10.1021/acs.jnatprod.9b00288. [DOI] [PubMed] [Google Scholar]
- 23.Huber C. The structure of stemphone, a yellow fungal metabolite. Acta Crystallogr B. 1975;31:108–113. doi: 10.1107/S056774087500218X. [DOI] [Google Scholar]
- 24.Chan J, Jamison TF. Synthesis of (−)-terpestacin via catalytic, stereoselective fragment coupling: siccanol is terpestacin, not 11-epi-terpestacin. J Am Chem Soc. 2003;125:11514–11515. doi: 10.1021/ja0373925. [DOI] [PubMed] [Google Scholar]
- 25.Nukina M, Hattori H, Marumo S. Cis-sativenediol, a plant growth promotor, produced by fungi. J Am Chem Soc. 1975;97:2542–2543. doi: 10.1021/ja00842a041. [DOI] [Google Scholar]
- 26.Li YY, Tan XM, Wang YD, Yang J, Zhang YG, Sun BD, Gong T, Guo LP, Ding G. Bioactive seco-sativene sesquiterpenoids from an Artemisia desertorum endophytic fungus, Cochliobolus sativus. J Nat Prod. 2020;83:1488–1494. doi: 10.1021/acs.jnatprod.9b01148. [DOI] [PubMed] [Google Scholar]
- 27.Osterhage C, König GM, Höller U, Wright AD. Rare sesquiterpenes from the algicolous fungus Drechslera dematioidea. J Nat Prod. 2002;65:306–313. doi: 10.1021/np010092l. [DOI] [PubMed] [Google Scholar]
- 28.Yu JJ, Jin YX, Huang SS, He J. Sesquiterpenoids and xanthones from the kiwifruit-associated fungus Bipolaris sp. and their anti-pathogenic microorganism activity. J Fungi. 2022;8:9. doi: 10.3390/jof8010009. [DOI] [PMC free article] [PubMed] [Google Scholar]
- 29.Wu M, Su X, Wu Y, Luo Y, Guo Y, Xue Y. Glycosylated coumarins, flavonoids, lignans and phenylpropanoids from Wikstroemia nutans and their biological activities. Beilstein J Org Chem. 2022;18:200–207. doi: 10.3762/bjoc.18.23. [DOI] [PMC free article] [PubMed] [Google Scholar]
- 30.Liu YP, Cai XH, Feng T, Li Y, Li XN, Luo XD. Triterpene and sterol derivatives from the roots of Breynia fruticose. J Nat Prod. 2011;74:1161–1168. doi: 10.1021/np2000914. [DOI] [PubMed] [Google Scholar]
- 31.Liu MT, Yan HE, Shen L, Hu ZX, Zhang YH. Bipolarins A-H, eight new ophiobolin-type sesterterpenes with antimicrobial activity from fungus Bipolaris sp. TJ403-B1. Chin J Nat Med. 2019;17(12):935–944. doi: 10.1016/S1875-5364(19)30116-5. [DOI] [PubMed] [Google Scholar]
- 32.Liu BQ, Wu YW, Qin DM, Wang HR, Chen HJ, Zhang Y, Xiao WL, Li XL, Wang RR, Zhang RH. Discovery of deguelin derivatives in combination with fluconazole against drug-resistant Candida albicans. Med Chem Res. 2023;32:2196–207. doi: 10.1007/s00044-023-03118-7. [DOI] [Google Scholar]
Associated Data
This section collects any data citations, data availability statements, or supplementary materials included in this article.
Supplementary Materials
Additional file 1: Fig. S1. 1H NMR spectrum of 1. Fig. S2. 13C NMR spectrum of 1. Fig. S3. HSQC spectrum of 1. Fig. S4. HMBC spectrum of 1. Fig. S5. 1H-1H COSY spectrum of 1. Fig. S6. ROESY spectrum of 1. Fig. S7. HRESIMS spectrum of 1. Fig. S8. IR spectrum of 1. Fig. S9. UV spectrum of 1. Fig. S10. 1H NMR spectrum of 2. Fig. S11. 13C NMR spectrum of 2. Fig. S12. HSQC spectrum of 2. Fig. S13. HMBC spectrum of 2. Fig. S14. 1H-1H COSY spectrum of 2. Fig. S15. ROESY spectrum of 2. Fig. S16. HRESIMS spectrum of 2. Fig. S17. IR spectrum of 2. Fig. S18. UV spectrum of 2. Fig. S19. 1H NMR spectrum of 3. Fig. S20. 13C NMR spectrum of 3. Fig. S21. HSQC spectrum of 3. Fig. S22. HMBC spectrum of 3. Fig. S23. 1H-1H COSY spectrum of 3. Fig. S24. ROESY spectrum of 3. Fig. S25. HRESIMS spectrum of 3. Fig. S26. IR spectrum of 3. Fig. S27. UV spectrum of 3. Fig. S28. 1H NMR spectrum of 4. Fig. S29. 13C NMR spectrum of 4. Fig. S30. HSQC spectrum of 4. Fig. S31 HMBC spectrum of 4. Fig. S32. 1H-1H COSY spectrum of 4. Fig. S33. ROESY spectrum of 4. Fig. S34. HRESIMS spectrum of 4. Fig. S35. IR spectrum of 4. Fig. S36. UV spectrum of 4. Fig. S37. 1H NMR spectrum of 5. Fig. S38. 13C NMR spectrum of 5. Fig. S39. HSQC spectrum of 5. Fig. S40. HMBC spectrum of 5. Fig. S41. 1H-1H COSY spectrum of 5. Fig. S42. ROESY spectrum of 5. Fig. S43. HRESIMS spectrum of 5. Fig. S44. IR spectrum of 5. Fig. S45. UV spectrum of 5. Fig. S46. 1H NMR spectrum of 6. Fig. S47. 13C NMR spectrum of 6. Fig. S48. HSQC spectrum of 6. Fig. S49. HMBC spectrum of 6. Fig. S50. 1H-1H COSY spectrum of 6. Fig. S51. ROESY spectrum of 6. Fig. S52. HRESIMS spectrum of 6. Fig. S53. IR spectrum of 6. Fig. S54. UV spectrum of 6. Fig. S55. 1H NMR spectrum of 7. Fig. S56. 13C NMR spectrum of 7. Fig. S57. 1H NMR spectrum of 8. Fig. S58. 13C NMR spectrum of 8. Fig. S59. 1H NMR spectrum of 9. Fig. S60. 13C NMR spectrum of 9. Fig. S61. 1H NMR spectrum of 10. Fig. S62. 13C NMR spectrum of 10. Fig. S63. 1H NMR spectrum of 11. Fig. S64. 13C NMR spectrum of 11. Fig. S65. 1H NMR spectrum of 12. Fig. S66. 13C NMR spectrum of 12. Fig. S67. 1H NMR spectrum of 13. Fig. S68. 13C NMR spectrum of 13. Fig. S69. 1H NMR spectrum of 14. Fig. S70. 13C NMR spectrum of 14. Fig. S71. 1H NMR spectrum of 15. Fig. S72. 13C NMR spectrum of 15. Fig. S73. 1H NMR spectrum of 16. Fig. S74. 13C NMR spectrum of 16. Fig. S75. 1H NMR spectrum of 17. Fig. S76 13C NMR spectrum of 17. Fig. S77. Correlations between calculated and experimental 13C NMR chemical shifts of 1A and 1B. Fig. S78. DP4 + analysis results of 1. Table S1. Energy analysis for conformers of 1Aa ~ 1Ae at mpw1pw91/6–31 + g(d,p) level in the gas phase. Table S2. Cartesian coordinates for the low-energy optimized conformers of 1A at M062X/def2svp level. Fig. S79. Correlations between calculated and experimental 13C NMR chemical shifts of 2A and 2B. Fig. S80. DP4 + analysis results of 2. Table S3. Energy analysis for conformers of 2Aa ~ 2Ae at mpw1pw91/6–31 + g(d,p) level in the gas phase. Table S4. Cartesian coordinates for the low-energy optimized conformers of 2A at M062X/def2svp level. Fig. S81. Correlations between calculated and experimental.13C NMR chemical shifts of 4A and 4B. Fig. S82. DP4 + analysis results of 4 Table S5. Energy analysis for conformers of 4Aa ~ 4Ae at mpw1pw91/6–31 + g(d,p) level in the gas phase Table S6. Cartesian coordinates for the low-energy optimized conformers of 4A at M062X/def2svp level. Table S7. Inhibitory effect of compounds on four strains of bacteria. Table S8. Inhibitory effect of compounds on five strains of Cytotoxicity.
Data Availability Statement
All data generated and analyzed during this study are included in this published article and its Additional file.